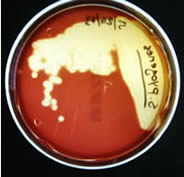
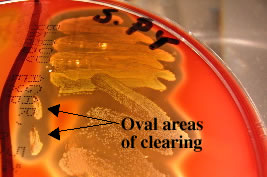

Summary of Biochemical Tests
Tests used to identify Gram Positive Bacteria- Catalase Test
- Mannitol Salt Agar (MSA)
- Blood Agar Plates (BAP)
- Streak-stab technique
- Taxos P (optochin sensitivity testing)
- Taxos A (bacitracin sensitivity testing)
- CAMP Test
- Bile Esculin Agar
- Nitrate Broth
- Spirit Blue agar
- Starch hydrolysis test
- Motility Agar
- Coagulase Test
- Oxidase Test
- Sugar (eg glucose) broth with Durham tubes
- Methyl Red / Voges-Proskauer (MR/VP)
- Kliger's Iron Agar (KIA)
- Nitrate Broth
- Motility Agar
- MacConkey agar
- Simmon's Citrate Agar
- Urease test
- Sulfur Indole Motility Media (SIM)
- Beta-hemolysis is complete hemolysis. It is characterized by a clear (transparent) zone surrounding the colonies. Staphylococcus aureus, Streptococcus pyogenes and Streptococcus agalactiae are b-hemolytic (the picture on the left below shows the beta-hemolysis of S. pyogenes).
- Partial hemolysis is termed alpha-hemolysis. Colonies typically are surrounded by a green, opaque zone. Streptococcus pneumoniae and Streptococcus mitis are a-hemolytic (the picture on the right below shows the a-hemolysis of S. mitis).
- If no hemolysis occurs, this is termed gamma-hemolysis. There are no notable zones around the colonies. Staphylococcus epidermidis is gamma-hemolytic.
- Microbiology, Sixth Edition by Prescott, Lansing M., Harley, John P., and Donald A. Klein. McGraw-Hill-Boston
- General Microbiology Laboratory Manual by Rachel Watson
Mannitol Salt Agar (MSA)
This type of medium is both selective and differential. The MSA will select for organisms such as Staphylococcus species which can live in areas of high salt concentration (plate on the left in the picture below). This is in contrast to Streptococcus species, whose growth is selected against by this high salt agar (plate on the right in the picture below).
The differential ingredient in MSA is the sugar mannitol. Organisms capable of using mannitol as a food source will produce acidic byproducts of fermentation that will lower the pH of the media. The acidity of the media will cause the pH indicator, phenol red, to turn yellow. Staphylococcus aureus is capable of fermenting mannitol (left side of left plate) while Staphylococcus epidermidis is not (right side of left plate).

Glucose broth with Durham tubes
This is a differential medium. It tests an organism's ability to ferment the sugar glucose as well as its ability to convert the end product of glycolysis, pyruvic acid into gaseous byproducts. This is a test commonly used when trying to identify Gram-negative enteric bacteria, all of which are glucose fermenters but only some of which produce gas.
Like MSA, this medium also contains the pH indicator, phenol red. If an organism is capable of fermenting the sugar glucose, then acidic byproducts are formed and the pH indicator turns yellow. Escherichia coli is capable of fermenting glucose as are Proteus mirabilis (far right) and Shigella dysenteriae (far left). Pseudomonas aeruginosa (center) is a nonfermenter.
The end product of glycolysis is pyruvate. Organisms that are capable of converting pyruvate to formic acid and formic acid to H2 (g) and CO2 (g), via the action of the enzyme formic hydrogen lyase, emit gas. This gas is trapped in the Durham tube and appears as a bubble at the top of the tube. Escherichia coli and Proteus mirabilis (far right) are both gas producers. Notice that Shigella dysenteriae (far left) ferments glucose but does not produce gas.
*Note - broth tubes can be made containing sugars other than glucose (e.g. lactose and mannitol). Because the same pH indicator (phenol red) is also used in these fermentation tubes, the same results are considered positive (e.g. a lactose broth tube that turns yellow after incubation has been inoculated with an organism that can ferment lactose).

Blood Agar Plates (BAP)
This is a differential medium. It is a rich, complex medium that contains 5% sheep red blood cells. BAP tests the ability of an organism to produce hemolysins, enzymes that damage/lyse red blood cells (erythrocytes). The degree of hemolysis by these hemolysins is helpful in differentiating members of the genera Staphylococcus, Streptococcus and Enterococcus.
Streak-stab technique
Often when inoculating a BAP to observe hemoloysis patterns, investigators will also stab several times through the agar using an inoculating loop. This stab allows for the detection of streptolysin O, a specific hemolysin produced by Streptococcus pyogenes. This hemolysin is inactivated by O2 and is only seen subsurface (in an anaerobic environment) around the stab mark. Note the oval-shaped areas of clearing around the stab marks in the picture below; these are caused by streptolysin O.
Bile Esculin Agar
This is a medium that is both selective and differential. It tests the ability of organisms to hydrolyze esculin in the presence of bile. It is commonly used to identify members of the genus Enterococcus (E faecalis and E. faecium).
The first selective ingredient in this agar is bile, which inhibits the growth of Gram-positives other than enterococci and some streptococci species. The second selective ingredient is sodium azide. This chemical inhibits the growth of Gram-negatives.
The differential ingredient is esculin. If an organism can hydrolyze esculin in the presence of bile, the product esculetin is formed. Esculetin reacts with ferric citrate (in the medium), forming a phenolic iron complex which turns the entire slant dark brown to black. The tube on the far right was inoculated with E. faecalis (positive). The tube in the center was inoculated with a bilie esculin negative organism and the tube on the left was uninoculated.

Sulfur Indole Motility Media (SIM)
This is a differential medium. It tests the ability of an organism to do several things: reduce sulfur, produce indole and swim through the agar (be motile). SIM is commonly used to differentiate members of Enterobacteriaceae.
Sulfur can be reduced to H2S (hydrogen sulfide) either by catabolism of the amino acid cysteine by the enzyme cysteine desulfurase or by reduction of thiosulfate in anaerobic respiration. If hydrogen sulfide is produced, a black color forms in the medium. Proteus mirabilis is positive for H2S production. The organism pictured on the far left is positive for hydrogen sulfide production.
Bacteria that have the enzyme tryptophanase, can convert the amino acid, tryptophane to indole. Indole reacts with added Kovac’s reagent to form rosindole dye which is red in color (indole +). Escherichia coli is indole positive. The organism pictured second from left is E. coli and is indole positive.
SIM tubes are inoculated with a single stab to the bottom of the tube. If an organism is motile than the growth will radiate from the stab mark and make the entire tube appear turbid. Pseudomonas aeruginosa and the strain of Proteus mirabilis that we work with are motile.

Catalase Test
This test is used to identify organisms that produce the enzyme, catalase. This enzyme detoxifies hydrogen peroxide by breaking it down into water and oxygen gas.
The bubbles resulting from production of oxygen gas clearly indicate a catalase positive result. The sample on the right below is catalase positive. The Staphylococcus spp. and the Micrococcus spp. are catalase positive. The Streptococcus and Enterococcus spp. are catalase negative.
Oxidase Test
This test is used to identify microorganisms containing the enzyme cytochrome oxidase (important in the electron transport chain). It is commonly used to distinguish between oxidase negative Enterobacteriaceae and oxidase positive Pseudomadaceae.Cytochrome oxidase transfers electrons from the electron transport chain to oxygen (the final electron acceptor) and reduces it to water. In the oxidase test, artificial electron donors and acceptors are provided. When the electron donor is oxidized by cytochrome oxidase it turns a dark purple. This is considered a positive result. In the picture below the organism on the right (Pseudomonas aeruginosa) is oxidase positive.
Urease test
This test is used to identify bacteria capable of hydrolyzing urea using the enzyme urease. It is commonly used to distinguish the genus Proteus from other enteric bacteria. The hydrolysis of urea forms the weak base, ammonia, as one of its products. This weak base raises the pH of the media above 8.4 and the pH indicator, phenol red, turns from yellow to pink. Proteus mirabilis is a rapid hydrolyzer of urea (center tube pictured here). The tube on the far right was inoculated with a urease negative organism and the tube on the far left was uninoculated.

Motility agar
It is a differential medium used to determine whether an organism is equipped with flagella and thus capable of swimming away from a stab mark. The results of motility agar are often difficult to interpret. Generally, if the entire tube is turbid, this indicates that the bacteria have moved away from the stab mark (are motile). The organisms in the two tubes pictured on the right are motile. If, however, the stab mark is clearly visible and the rest of the tube is not turbid, the organism is likely nonmotile
